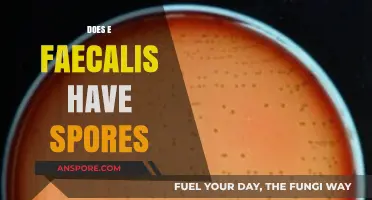
Does E. Faecalis Form Spores? Unraveling the Truth and Implications

Disinfectants are commonly used to kill bacteria, viruses, and other pathogens, but their effectiveness against mould spores is a topic of significant interest and debate. Mould spores are highly resilient and can survive in harsh conditions, making them particularly challenging to eradicate. While some disinfectants, such as those containing bleach or hydrogen peroxide, can kill mould on surfaces, they may not always eliminate spores entirely. Mould spores can remain dormant and reactivate under favorable conditions, leading to recurring mould growth. Therefore, understanding the limitations of disinfectants and the necessity of additional measures, such as proper ventilation and moisture control, is crucial for effectively managing mould infestations.
| Characteristics | Values |
|---|---|
| Effectiveness of Disinfectants | Most disinfectants can kill mould but are less effective on spores. |
| Type of Disinfectants | Bleach, hydrogen peroxide, and quaternary ammonium compounds are commonly used. |
| Effect on Mould Spores | Disinfectants may kill active mould but often do not eliminate spores. |
| Spores' Resistance | Mould spores are highly resistant to disinfectants due to their protective outer layer. |
| Recommended Approach | Physical removal of mould and spores is more effective than relying solely on disinfectants. |
| Prevention | Reducing moisture and improving ventilation are key to preventing mould growth. |
| Health Risks | Mould spores can cause allergies, respiratory issues, and other health problems. |
| Professional Intervention | Severe mould infestations may require professional remediation services. |
| Environmental Factors | Mould thrives in damp, humid, and poorly ventilated environments. |
| Long-Term Solution | Addressing the root cause of moisture is essential for long-term mould prevention. |
Explore related products
What You'll Learn

Effectiveness of bleach on mould spores
Bleach, a common household disinfectant, is often the first remedy homeowners reach for when tackling mould. Its active ingredient, sodium hypochlorite, is effective at killing surface mould but falls short on porous materials like drywall or wood. When applied correctly—typically a solution of 1 cup bleach per gallon of water—it can eliminate visible mould on non-porous surfaces like tiles or glass. However, bleach’s effectiveness diminishes on rough or absorbent surfaces because it doesn’t penetrate deeply enough to kill spores embedded beneath the surface. This limitation often leads to recurring mould growth if the root cause isn’t addressed.
To use bleach effectively, follow these steps: mix the solution, apply it directly to the mouldy area using a spray bottle or cloth, let it sit for 10–15 minutes, then scrub with a brush and rinse thoroughly. Always wear protective gear, including gloves and a mask, as bleach fumes can be harmful. Avoid using bleach in areas with poor ventilation or around children and pets. While it’s a quick fix for surface mould, it’s not a long-term solution for porous materials or extensive infestations.
Comparatively, bleach is more effective than vinegar for killing mould spores but less so than specialized mould removers containing benzalkonium chloride or hydrogen peroxide. Vinegar, a natural alternative, lacks the potency to kill spores, while hydrogen peroxide penetrates surfaces better than bleach, making it superior for porous materials. Bleach’s primary advantage is its accessibility and affordability, but its limitations highlight the need for tailored solutions depending on the surface and severity of the mould.
A critical takeaway is that bleach addresses the symptom—visible mould—but not always the cause. Mould thrives in damp environments, so fixing leaks, improving ventilation, and reducing humidity are essential preventive measures. For severe cases, professional remediation may be necessary to ensure spores are fully eradicated. While bleach has its place in mould control, it’s a tool, not a cure-all, and its effectiveness depends on proper application and context.
Village Warfare in Spore: Do Settlements Engage in Conflict?
You may want to see also

Role of hydrogen peroxide in spore removal
Hydrogen peroxide, a household staple often relegated to first-aid kits, emerges as a potent weapon against mold spores. Its efficacy stems from its oxidizing power, which disrupts the cellular structure of spores, rendering them incapable of germination and growth. Unlike some disinfectants that merely inhibit surface mold, hydrogen peroxide penetrates porous materials, reaching spores hidden beneath the surface. This makes it particularly effective for treating mold on fabrics, wood, and grout, where spores often embed themselves.
Dosage and Application: For optimal spore removal, a 3% hydrogen peroxide solution is recommended. This concentration strikes a balance between effectiveness and safety, minimizing the risk of material damage. Apply the solution directly to the affected area, allowing it to sit for 10-15 minutes before wiping away. For stubborn mold, repeat the process. Always test on a small, inconspicuous area first to ensure compatibility with the material.
While hydrogen peroxide excels at spore removal, its effectiveness hinges on proper application. Cautions: Hydrogen peroxide can bleach certain fabrics and discolor surfaces, particularly those with natural dyes. Avoid using it on wool, silk, or leather. Additionally, its oxidizing nature can weaken certain materials over time, so frequent use on the same area is not advisable. Always wear gloves and ensure adequate ventilation when working with hydrogen peroxide, as it can irritate skin and eyes.
Comparative Advantage: Compared to bleach, another common mold remedy, hydrogen peroxide offers several advantages. It's less corrosive, safer for colored fabrics, and doesn't produce harmful fumes. Furthermore, it decomposes into water and oxygen, leaving no toxic residue, making it a more environmentally friendly option.
Practical Tips: For preventative measures, incorporate hydrogen peroxide into your regular cleaning routine. Wipe down shower walls and grout lines weekly to inhibit mold growth. For areas prone to moisture, like basements and bathrooms, consider using a hydrogen peroxide-based cleaner as a proactive measure. Remember, while hydrogen peroxide is a powerful tool, it's not a magic bullet. Addressing the underlying cause of moisture is crucial for long-term mold prevention.
Where to Locate Your Spore CD Key on Steam: A Quick Guide
You may want to see also

Impact of vinegar on mould survival
Vinegar, a household staple, is often touted as a natural remedy for mould removal. Its acidic nature, primarily due to acetic acid, is believed to disrupt the cellular structure of mould, making it a popular choice for DIY cleaning solutions. However, its effectiveness against mould spores—the resilient, dormant forms of mould—is a subject of debate. While vinegar can kill active mould growth on surfaces, its impact on spores is less definitive. Spores are designed to withstand harsh conditions, and vinegar’s acidity, though potent, may not always penetrate their protective outer layers.
To use vinegar effectively against mould, dilution matters. A solution of 1 part vinegar to 1 part water is commonly recommended for surface cleaning. For more stubborn mould, undiluted vinegar can be applied directly, left for an hour, and then scrubbed away. However, this method is best suited for non-porous surfaces like tiles or glass. Porous materials, such as wood or drywall, may absorb the vinegar, leading to lingering odors or incomplete mould removal. In these cases, vinegar’s efficacy is limited, and professional remediation may be necessary.
Comparatively, vinegar falls short when pitted against commercial disinfectants specifically formulated to kill mould spores. Products containing bleach, hydrogen peroxide, or quaternary ammonium compounds are often more effective due to their stronger antimicrobial properties. However, vinegar’s appeal lies in its safety and accessibility. Unlike harsh chemicals, it is non-toxic, making it a preferred option for households with children, pets, or individuals sensitive to fumes. Its eco-friendly nature also aligns with sustainable cleaning practices.
A practical tip for maximizing vinegar’s impact is to combine it with physical removal techniques. After applying vinegar, scrubbing the area with a stiff brush helps dislodge spores and surface mould. Following this, wiping the area with a clean, damp cloth ensures residue removal. For preventive measures, regularly spraying vinegar in mould-prone areas like bathrooms or kitchens can inhibit initial mould growth. However, for severe infestations, vinegar should be seen as a supplementary tool rather than a standalone solution.
In conclusion, while vinegar can be effective against active mould, its ability to kill spores is inconsistent. Its strengths lie in its safety, accessibility, and suitability for minor mould issues. For comprehensive mould control, especially in porous materials or large-scale infestations, combining vinegar with other methods or opting for specialized disinfectants is advisable. Understanding vinegar’s limitations ensures its proper application, balancing natural remedies with practical effectiveness.
Can Toxic Mold Spore Penetrate Drywall? Facts and Risks Revealed
You may want to see also
Explore related products
$13.48 $14.13

Alcohol-based disinfectants and spore eradication
Alcohol-based disinfectants, commonly found in household cleaners and sanitizers, are often touted for their effectiveness against bacteria and viruses. However, their efficacy against mold spores is a different matter entirely. Mold spores are remarkably resilient, protected by a tough outer layer that allows them to survive harsh conditions. While alcohol can disrupt the cell membranes of many microorganisms, its ability to penetrate and destroy the protective coating of mold spores is limited. This means that while alcohol-based disinfectants may kill surface mold, they often fail to eradicate the spores themselves, leaving the potential for regrowth.
To understand why alcohol falls short, consider its mechanism of action. Ethanol, the most common alcohol in disinfectants, works by denaturing proteins and dissolving lipids, effectively destroying the structure of many pathogens. However, mold spores have evolved to withstand desiccation and environmental stressors, making them less susceptible to alcohol’s effects. Studies show that concentrations of 70% isopropyl alcohol, a standard in many disinfectants, can reduce mold spore viability but do not guarantee complete eradication. For instance, *Aspergillus* and *Penicillium* spores, common household molds, have been observed to survive exposure to alcohol-based solutions.
If you’re considering using alcohol-based disinfectants for mold control, follow these steps for optimal results: first, clean the affected area with soap and water to remove visible mold. Next, apply a 70% isopropyl alcohol solution, allowing it to sit for at least 10 minutes to maximize its antimicrobial effect. Wipe the area thoroughly and ensure proper ventilation during application. However, be cautious: alcohol is flammable and should never be used near open flames or heat sources. Additionally, while it may help manage surface mold, it is not a long-term solution for spore eradication.
A comparative analysis highlights the limitations of alcohol-based disinfectants when pitted against alternatives like bleach or hydrogen peroxide. Bleach, for instance, contains sodium hypochlorite, which oxidizes and destroys mold spores effectively. Hydrogen peroxide, another oxidizing agent, also outperforms alcohol in spore eradication. These alternatives are more reliable for preventing mold recurrence, though they come with their own risks, such as skin irritation or surface discoloration. Alcohol’s advantage lies in its safety and versatility, making it suitable for quick surface disinfection but inadequate for deep mold remediation.
In conclusion, while alcohol-based disinfectants have their place in household cleaning, they are not the go-to solution for mold spore eradication. Their effectiveness is limited by the spores’ resilience, and reliance on alcohol alone can lead to recurring mold issues. For persistent mold problems, consider professional remediation or stronger antifungal agents. Use alcohol as a supplementary measure, not a primary treatment, and always address the underlying moisture issues that foster mold growth. Practicality and safety make alcohol a useful tool, but its role in mold control is narrowly defined.
Can Mold Spores Penetrate Fiberglass? Understanding Risks and Prevention
You may want to see also

Chlorine-based cleaners vs. mould spores
Chlorine-based cleaners, such as bleach, are often the first line of defense against mold due to their potent antimicrobial properties. These cleaners work by oxidizing the cells of mold spores, effectively breaking them down and rendering them inactive. A typical household bleach solution (1 cup of bleach per gallon of water) is sufficient for most mold remediation tasks on non-porous surfaces like tiles, glass, and countertops. However, while chlorine-based cleaners are effective at killing surface mold, they have limitations. Mold spores can penetrate porous materials like wood, drywall, and fabric, where bleach cannot fully penetrate, leaving spores intact and capable of regrowth.
The effectiveness of chlorine-based cleaners also depends on proper application. Surfaces must remain wet with the bleach solution for at least 10 minutes to ensure mold spores are fully neutralized. This requires careful timing and attention, as insufficient contact time may only temporarily suppress mold growth. Additionally, chlorine-based cleaners release fumes that can be harmful if inhaled, necessitating adequate ventilation and protective gear like gloves and masks. For individuals with respiratory sensitivities or asthma, these fumes can exacerbate health issues, making alternative mold-fighting methods more appealing.
Comparatively, chlorine-based cleaners are more cost-effective than many specialized mold removal products, making them a popular choice for homeowners. However, their harsh nature can discolor or damage certain materials, such as colored fabrics or finished wood surfaces. This trade-off between efficacy and potential damage highlights the importance of testing chlorine-based cleaners on a small, inconspicuous area before full application. For porous or delicate materials, professional remediation or alternative solutions like vinegar or hydrogen peroxide may be more suitable.
Despite their limitations, chlorine-based cleaners remain a powerful tool in the fight against mold spores, particularly in high-moisture areas like bathrooms and kitchens. To maximize their effectiveness, combine their use with preventive measures such as reducing indoor humidity levels (below 60%), fixing leaks promptly, and ensuring proper ventilation. While they may not be a one-size-fits-all solution, chlorine-based cleaners offer a practical and accessible option for tackling mold growth when used correctly and in appropriate contexts.
Are Mould Spores Airborne? Unveiling the Truth About Indoor Air Quality
You may want to see also
Frequently asked questions
Most common household disinfectants are not specifically designed to kill mould spores. While they may kill surface mould, spores are more resistant and often require specialized mould-killing products or fungicides.
Bleach can kill surface mould but is not highly effective against mould spores. It may temporarily remove visible mould but does not penetrate porous surfaces where spores can remain and regrow.
Products containing fungicides, such as those with benzalkonium chloride or specific mould remediation sprays, are more effective at killing mould spores. Professional mould removal may be necessary for severe infestations.